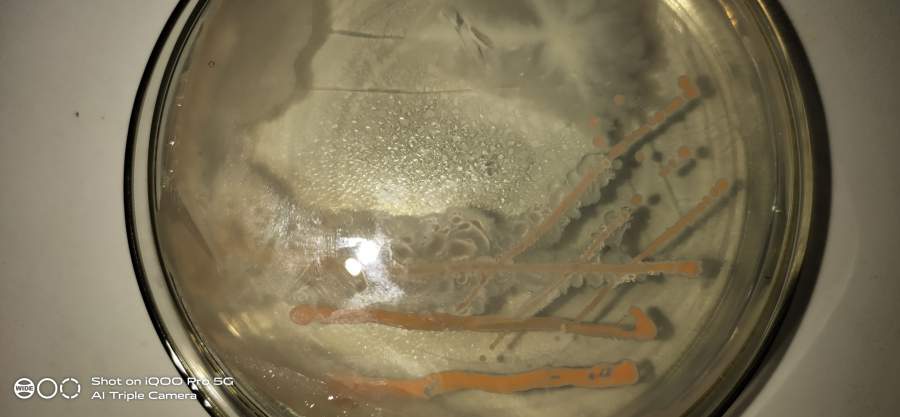
细菌鉴定,急急急!!!
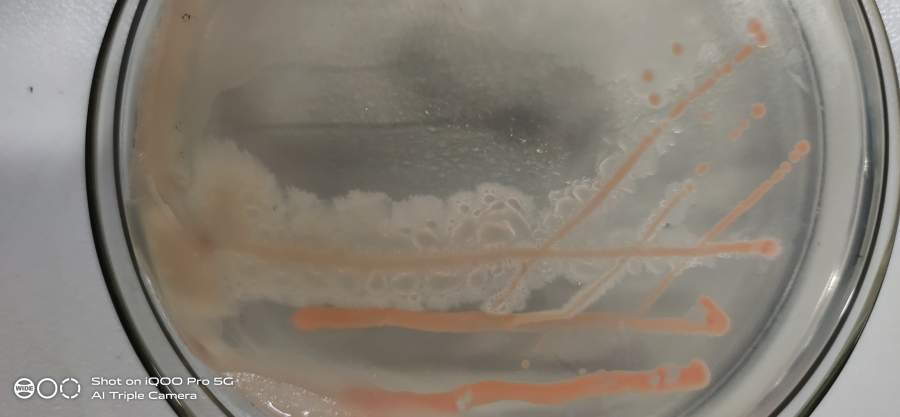
细菌鉴定,急急急!!!-1
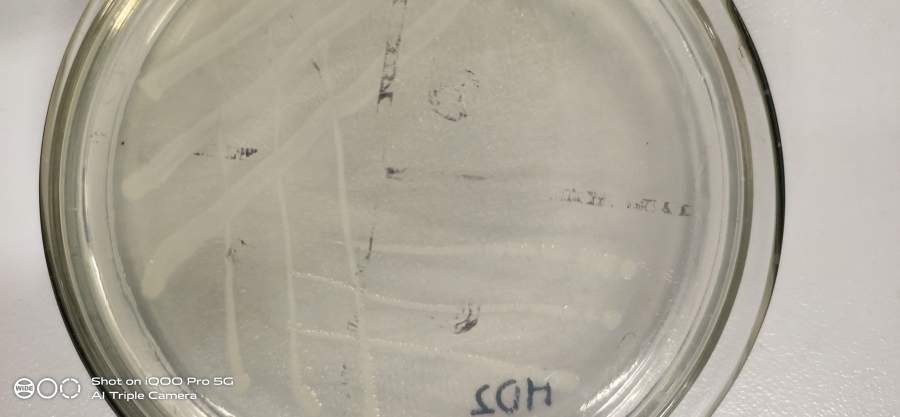
细菌鉴定,急急急!!!-4

细菌鉴定,急急急!!!
各位研究微生物的朋友们,你们知道这是什么菌吗?本人从事抗生素降解菌研究,初次筛选出几株菌,想请教一下大家。

IMG_20200711_205352.jpg

IMG_20200711_205412.jpg

IMG_20200711_205433.jpg

IMG_20200711_205445.jpg

IMG_20200711_205450.jpg
返回小木虫查看更多
今日热帖
各位研究微生物的朋友们,你们知道这是什么菌吗?本人从事抗生素降解菌研究,初次筛选出几株菌,想请教一下大家。
IMG_20200711_205352.jpg
IMG_20200711_205412.jpg

IMG_20200711_205433.jpg

IMG_20200711_205445.jpg
IMG_20200711_205450.jpg
返回小木虫查看更多
图2和我之前做的Bt菌株好相啊
测一下16s
腊状的那个很像芽孢,可以测一下功能序列
很像是芽孢杆菌,提个DNA测个16S,得到的序列去NCBI比对下就知道了,也不贵,
好的